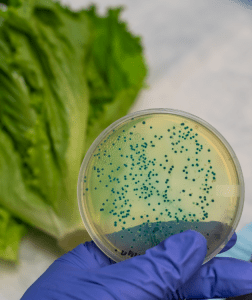

Smart Food Safe participating in SQF Unites 2025, from March 2nd - 5th, 2025 at the Hyatt Regency, Orlando, Florida. Meet us at Booth #16
Smart Food Safe participating in SQF Unites 2025, from March 2nd - 5th, 2025 at the Hyatt Regency, Orlando, Florida. Meet us at Booth #16
Smart Food Safe participating in SQF Unites 2025, from March 2nd - 5th, 2025 at the Hyatt Regency, Orlando, Florida. Meet us at Booth #16
Smart Food Safe participating in
Food Safety Summit Conference & Expo from May 12th to 15th in Rosemont, IL. Meet us at Booth #602.